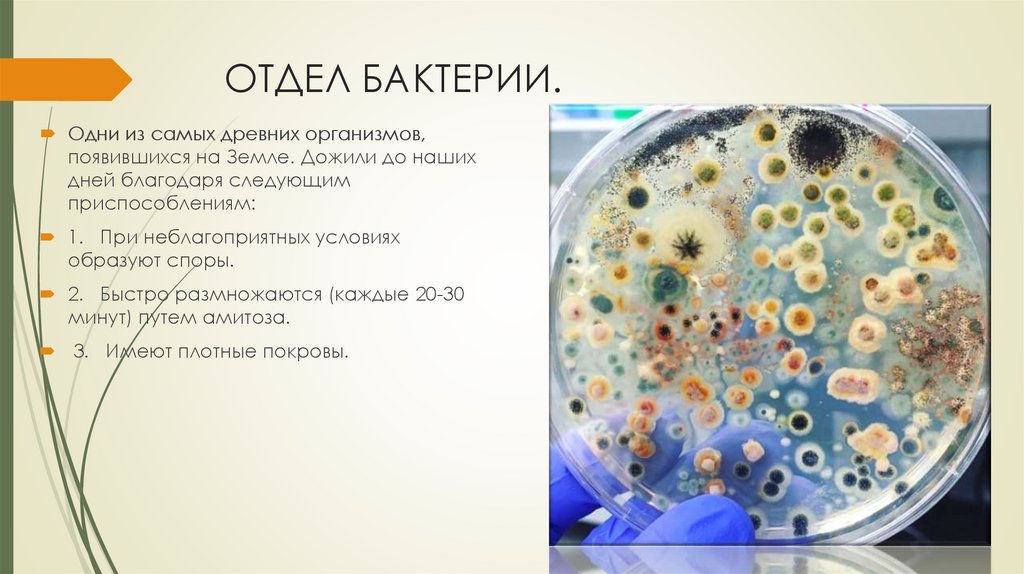

Similar presentations:
Бактерии. Отдел бактерии
1.
Бактерии2.
ОТДЕЛ БАКТЕРИИ.Одни из самых древних организмов,
появившихся на Земле. Дожили до наших
дней благодаря следующим
приспособлениям:
1. При неблагоприятных условиях
образуют споры.
2. Быстро размножаются (каждые 20-30
минут) путем амитоза.
3. Имеют плотные покровы.
3.
Относятся бактерии к надцарствупрокариот:
не имеют обособленного ядра
цитоплазма покрыта плазматической
мембраной, выпячивания которой
(мезосомы) выполняют роль митохондрий,
ЭПС и аппарата Гольджи.
Бактериальная клетка покрыта оболочкой,
которая состоит из плазматической
мембраны, клеточной стенки и капсулы.
Плазматическая мембрана обладает
свойством полупроницаемости и
обеспечивает избирательное поступление
веществ в клетку и выведение продуктов
обмена, а также образует мезосомы, на
мембранах мезосом располагаются
окислительно-восстановительные
ферменты.
4.
Строение бактериальной клеткиКлеточная стенка обеспечивает постоянство
формы и состоит из полисахаридов,
защищает от воздействия неблагоприятных
условий.
Снаружи клетка окружена слизистой
капсулой, защищающей ее от высыхания.
В цитоплазме находятся рибосомы и
включения - запасные питательные вещества.
В центре клетки расположен нуклеоид,
содержащий одну хромосому, замкнутую в
виде спирали, неограниченную от
цитоплазмы ядерной оболочкой.
Эта хромосома является носителем
наследственной информации.
5.
Строение бактериальной клеткиНекоторые бактерии имеют
органоиды движения - жгутики,
которые состоят из особого
белка - флагеллина.
У некоторых бактерий, лишенных
жгутиков (у водных и почвенных), в
цитоплазме есть газовые
вакуоли, заполненные азотом, за
счет них клетка поднимается или
опускается, регулируя количество
газа в вакуолях.
6.
Бактерии размножаются путем деления клетки на двечасти (амитоз, посредством перетяжки).
Цилиндрические формы делятся
поперек
шаровидные - в любом
направлении.
Некоторые бактерии размножаются
почкованием
половой процесс отмечен лишь в
немногих случаях (кишечная
палочка).
Передача генетического материала
происходит из одной клетки в другую
при непосредственном контакте (по
типу конъюгации).
Количество особей при этом не
увеличивается, но происходит
обмен наследственной
информации.
7.
Споры бактерийПри наступлении неблагоприятных
условий бактерии способны
образовывать споры, в ней уменьшается
количество воды, содержимое клетки
сжимается и покрывается плотной
оболочкой.
Споры способны сохранять
жизнеспособность в течение многих лет.
Они переносят высушивание, резкую
перемену температуры, действие
ядовитых веществ.
В благоприятных условиях споры
набухают, оболочка разрывается, и
клетка выходит наружу.
8.
Бактерии распространеныповсеместно:
в воздухе,
почве,
воде,
снегах,
горячих источниках,
с температурой воды до
90°С.
Особенно много их в почве
от 200 млн. до 2 млрд. в 1
грамме почвы.
Распространение в воде и
воздухе зависит от степени
загрязнения сред.
9.
Формы бактерий разнообразны:шаровидные – кокки
палочковидные – бациллы
изогнутые – вибрионы спириллы;
кокки, сцепленные попарно, диплококки,
цепочки - стрептококки,
в виде гроздей - стафилококки.
10.
БактерииБактерии были открыты Антоном
Левенгукком в 1671 году
Луи Пастер показал:
их роль в процессе брожения
круговороте веществ
установил, что бактерии являются
возбудителями заболеваний
животных и человека.
11.
По способу питания бактерииделятся на:
Фотосинтетики - пурпурные и
зеленые бактерии
содержат пигмент
бактериохлорофилл, при участии
которого происходит фотосинтез
но фотолиза воды при этом не
происходит и молекулярный
кислород не выделяется
используется энергия солнца.
12.
По способу питания бактерииделятся на:
Хемосинтетики - азотофиксирующие
бактерии, серобактерии и
железобактерии.
Наибольшее значение в природе
имеют азотофиксирующие бактерии,
они используют аммиак,
выделяющийся в процессе гниения.
При окислительных реакциях выделяют
небольшое количество энергии,
которое используется для синтеза
органических веществ.
хемосинтетики
Железобактерии
Нитрифицирующие
бактерии
Серобактерии
Образуют болотную
железную руду
Обеспечивают
растения
доступными
формами азота
Разрушают горные
породы
13.
По способу питания бактерииделятся на:
Сапрофиты - бактерии гниения
используют азотосодержащие
вещества
а бактерии брожения углеродсодержащие вещества.
14.
По способу питания бактерииделятся на:
Паразиты - бактерии, живущие за
счет живой клетки
вызывая болезни животных и
человека.
15.
По способу получения энергии(диссимиляции) различают:
анаэробные бактерии, живущие в
бескислородной среде, и получающие
энергию за счет бескислородного этапа
(ботулизм, столбняк, молочнокислые).
Аэробные - живут в кислородной среде, в
результате кислородного расщепления
органических веществ (дыхания) бактерии
образуют промежуточные вещества аминокислоты, витамины, жирные кислоты.
16.
ЗНАЧЕНИЕ БАКТЕРИЙ.1. Участвуют в круговороте веществ в природе. Луи Пастер назвал их
"великими могильщиками природы".
2. Вместе с грибами, водорослями и лишайниками участвуют в
почвообразовательных процессах.
3.
Бактерии способны обогащать почву азотом, свободно живущий
азотобактер способен связывать свободный молекулярный азот,
клубеньковые бактерии, поселяющиеся на корнях бобовых растении.
4. В пищевой промышленности используются бактерии молочнокислого
брожения (анаэробные) для получения простокваши, кефира и др.
Образующаяся молочная кислота препятствует развитию гнилостных
бактерий и обеспечивает сохранность продуктов. Бактерии широко
используются для промышленного получения молочной, уксусной кислот,
ацетона.
5. В процессе жизнедеятельности бактерий образуются биологически
активные вещества - антибиотики, витамины, аминокислоты.
6. Отрицательная роль принадлежит болезнетворным бактериям, они
способны проникать в ткани растений, животных и человека, выделять
вещества, угнетающие защитные силы организма (чума, холера,
туберкулезная палочка, сибирская язва). Поражают бактерии и растения,
вызывая бактериозы (пятнистость, мокрой гнили) у картофеля, плодовых
деревьев, капусты, огурцов.
7. Отрицательную роль играют бактерии гниения, вызывающие порчу
продуктов. Меры борьбы с ними: высушивание, замораживание,
маринование, пастеризация и др.. Для дезинфекции используется йод,
борная кислота, карболовые кислоты, спирт.

biology
biology








